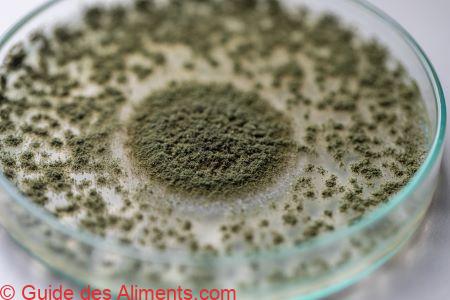
aspergillus oryzae (kôji-kin)

L’Aspergillus oryzae, également connu sous le nom de kōji-kin en japonais, est une espèce de champignons microscopiques, de la famille des Trichocomaceae. C’est une moisissure utilisée dans la gastronomie asiatique, en particulier dans la cuisine japonaise, pour la fermentation de divers produits alimentaires.
Voici une description de l’Aspergillus oryzae en gastronomie :
- Rôle dans la fermentation : L’Aspergillus oryzae est une moisissure qui joue un rôle crucial dans la fermentation de plusieurs ingrédients alimentaires. Elle est utilisée pour cultiver le kōji, une moisissure cultivée sur des grains de riz, de blé ou de soja. Le kōji est ensuite utilisé pour fermenter d’autres aliments tels que le miso, la sauce soja, le saké et le vinaigre de riz.
- Aspect : En culture, l’Aspergillus oryzae se présente sous la forme de spores blanches qui se développent sur le substrat (riz, blé ou soja). Ces spores produisent des enzymes qui décomposent l’amidon en sucres simples, facilitant ainsi la fermentation.
- Arôme et saveur : L’Aspergillus oryzae ne contribue pas directement à l’arôme ou à la saveur des aliments, mais elle est essentielle pour produire des composés aromatiques complexes pendant le processus de fermentation. Ces composés confèrent aux aliments fermentés des notes umami, salées, sucrées et souvent complexes.
- Produits fermentés : L’utilisation de l’Aspergillus oryzae est courante dans la production de différents produits alimentaires. Par exemple, dans la fabrication du miso, le kōji est mélangé avec des fèves de soja cuites et du sel, puis fermenté pendant plusieurs mois. De même, dans la production de la sauce soja, le kōji est utilisé pour fermenter un mélange de soja et de blé. Le kôji-kin est également un ingrédient indispensable dans le processus de fabrication du kurozu.
- Variétés : Il existe différentes souches d’Aspergillus oryzae, chacune apportant des caractéristiques spécifiques au processus de fermentation. La sélection de la souche peut influencer la saveur, l’arôme et la texture du produit final.
- Héritage culinaire : L’utilisation de l’Aspergillus oryzae dans la fermentation est une pratique ancienne qui remonte à des siècles dans la cuisine asiatique. Cette moisissure est un élément fondamental de la tradition alimentaire japonaise, contribuant à la création de nombreux produits fermentés emblématiques.
En résumé, l’Aspergillus oryzae, également connu sous le nom de kōji-kin, est une moisissure essentielle dans la production de nombreux produits alimentaires fermentés dans la cuisine asiatique, ajoutant des saveurs complexes et des arômes uniques à des ingrédients de base tels que le riz, le blé et le soja.
GUIDE DES ALIMENTS.COM | ALL RIGHTS RESERVED | ©

Sautés ou Poêlés : La méthode la plus classique pour savourer les
Sautés ou Poêlés : La méthode la plus classique pour savourer les 
 Composition
Composition
 1. Aspect et Texture
1. Aspect et Texture 1. Préparation
1. Préparation

 2. Principales Variétés
2. Principales Variétés
 Conservation et Disponibilité
Conservation et Disponibilité










 Composition et Variétés
Composition et Variétés
 Modes de cuisson
Modes de cuisson


 Chair
Chair
 Chapeau
Chapeau



 🍽️ Usages culinaires
🍽️ Usages culinaires
 🌿 Composition et caractéristiques botaniques
🌿 Composition et caractéristiques botaniques 🔪 Préparation et usages culinaires
🔪 Préparation et usages culinaires 👄 Texture et saveurs
👄 Texture et saveurs 🎎 Symbolisme culturel
🎎 Symbolisme culturel
 Aspect : L’
Aspect : L’ Plats Célèbres : Les
Plats Célèbres : Les 

 Description et caractéristiques
Description et caractéristiques




 Aspect physique : Le
Aspect physique : Le  Confusion : Bien que le
Confusion : Bien que le 
 Aspect : Le Matsutake a un chapeau généralement de couleur brun-jaune à brun-rougeâtre. Le chapeau est souvent couvert d’écailles ou de fibrilles et peut mesurer de quelques centimètres à une dizaine de centimètres de diamètre. Le pied est ferme, cylindrique et souvent bulbeux à la base.
Aspect : Le Matsutake a un chapeau généralement de couleur brun-jaune à brun-rougeâtre. Le chapeau est souvent couvert d’écailles ou de fibrilles et peut mesurer de quelques centimètres à une dizaine de centimètres de diamètre. Le pied est ferme, cylindrique et souvent bulbeux à la base.
 Chapeau : Le chapeau du
Chapeau : Le chapeau du 
 Apparence et identification
Apparence et identification Sauces et crèmes : Les
Sauces et crèmes : Les 



 Aspect : Le
Aspect : Le 



 Chapeau : L’
Chapeau : L’ Cuisson : L’
Cuisson : L’




 Apparence :
Apparence :







 Le
Le 



 Aspect : Le
Aspect : Le 



 La
La  Goût : La
Goût : La  Propriétés nutritives : La
Propriétés nutritives : La 

 Forme et apparence : La
Forme et apparence : La 



















